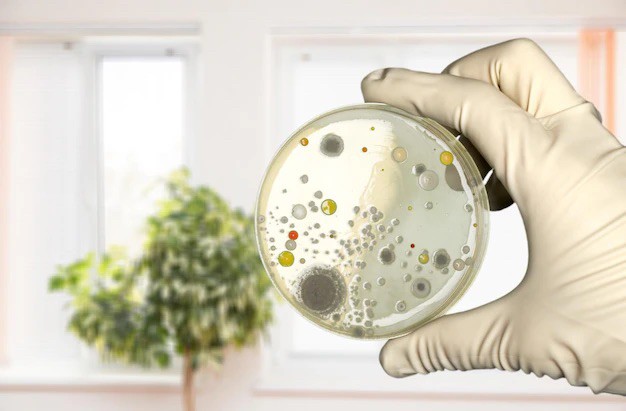

雖然我是心臟科醫師,但一向對失眠的問題很有興趣,會盡量幫患者調整生活習慣,或幫忙轉介身心科醫師治療。 除了因為我從高中時期就對心理學很有興趣以外,多年前當住院醫師的一段遭遇,也讓我與失眠症有了不解之緣。
當時在感染科訓練的時候,有照顧一位21歲的檳榔西施,她是真的賣檳榔的小姐,但因為感染了細菌性心內膜炎而住院,一次住院一個多月打抗生素治療 病情穩定之後我問她為什麼得到這樣可怕的疾病,她說因為長期失眠,吃安眠藥壓不住,後來認識了有毒品前科的男友,因此而開始打海洛因幫助睡眠。 我也嘗試幫她開一些安眠藥試試看,但是用了我們常規的兩三倍劑量,都沒有效果。 我很擔心她出院之後又再度施打毒品,趕緊幫她照會醫院的身心科主任,主任了解病情之後,只開了三種藥,就讓患者一夜好眠,而且之後每天晚上都睡的很好。
那個配方不是只有安眠藥,而是有加入一些焦慮調整的藥品,因此對她特別有效。 後來患者開心地出院了⋯⋯比起剛住院時瘦得像猴子一樣,簡直是判若兩人。 她送了我一張鑲金箔的卡片,跟我說她重生了,也戒毒成功了
所以失眠對某些的人來說是非常非常嚴重的情況,要好好治療 細菌性心內膜炎更是嚴重的心臟疾病,一次抗生素都可能要打一個月以上,請和醫生好好配合,不然心臟變差之後,一發不可收拾拾,甚至要手術才有辦法治療
#可怕的心內膜炎
#失眠學問大
推薦文章
拜託別再害您的主治醫師了! | 宇平診所
下床的時候下錯邊 | 宇平診所
宇平診所的藥物都沒有令人擔心的成分 | 宇平診所
醫療經濟學 | 宇平診所
門診時間
一
二
三
四
五
六
早 8:00-12:00
劉中平李幸容
劉中平
劉中平李幸容
劉中平李幸容
劉中平
劉中平
午 15:00-18:00
劉中平
劉中平李幸容
劉中平
劉中平
劉中平李幸容
休
晚 18:00-20:00
劉中平
劉中平李幸容
劉中平
劉中平
劉中平李幸容
休